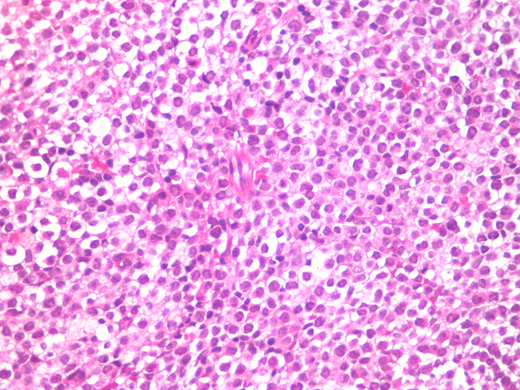
Figure

Introduction
Acute promyelocytic leukemia (APL) with PML-RARα is a variant type of acute myeloid leukemia (AML), halting granulocytes at the promyelocytic stage1, primarily associated with the t(15;17)(q22;q11-12) translocation2. The fusion gene BCR-ABL1, attributed to the t(9;22) translocation, is widely associated with chronic myeloid leukemia (CML)3, but rarely found in APL. In this report we explore the occurrence of both BCR/ABL and PML-RARα and in a patient with ongoing treatment for confirmed CML.
Case report
A 25-year-old woman with ongoing treatment for chronic myeloid leukaemia (CML) in use of Imatinib. Presented to the ER with fever, metrorrhagia, splenomegaly, cutaneous mycosis by Fusarium sp. Investigation upon admission showed pancytopenia, complete blood count showed white blood cells 1.290/mm3, hemoglobin 7,5 g/dL and platelets 13.000/mm3. Bone marrow trephine biopsy showed diffuse infiltration by blasts with large nuclei - round to oval, some irregular, some invaginated- and with hypergranulated cytoplasm(Fig. 01). The bone marrow aspiration showed hypocelular marrow with 67,9% pathological blasts (MPO++, CD13+, CD33++, CD117+, , CD34 -/+, CD15-, CD11b-). Chromosome analysis displayed 46, XX, t(9;22) (q34;q11) and t(15;17)(q22;q11-12). PCR showed amplification for both PML/RARα and BCR/ABL.
The patient was treated under Intensive Care with DA regimen and nilotimib associated retinoic acid (ATRA), as well as cefepime, metronidazole, B Amphotericin and vancomycin for cellulitis and fusariosis. The patient was discharged after fifty-three days in good clinical condition, and followed the treatment with consolidation phase therapy and presented remission of both CML and APL.
After two years in good clinical conditions, follow-up exams evidentiated new onset of APL (PCR with only t(15;17)(q22;q11-12) and BCR-ABL negative). Due the new condition, the patient is undergoing therapy with arsenic trioxide (ATO) (10mg/d) with good improvement of clinical conditions and a bone marrow transplant is scheduled at this point.
Discussion
Late progression of CML emcompasses uncontrolled proliferation and loss of control mechanisms and of differentiation, in a terminal status termed acutephase or blast crisis, typically resembling acute myeloid leukemia (AML)4. The presence of t(15;17)(q22;q11-12) translocation, closely associated with the diagnosis of PML (over 95% of cases), and t(9;22)(q34;q11) creates a fusion gene between BCR on chromosome 22 and ABL1 on chromosome 9 (BCR-ABL1), that is present in the wide majority of patients affected by CML1.
The rarity of PML in CML patients, associated with similarity between acute phase CML (AML-like) and PML, may cause confusion among clinicians and a difficult treatment course, since PML and CML follow different treatment protocols. Unlike other forms of myeloid leukemia, APL substantially improves in response with the combination of ATO and ATRA, with or without chemotherapy, achieving complete remission rates of ≥95% with 2-year overall survival >90%1, while treatment of CML have tyrosine kinase inhibitors with assessment of molecular response as the primary therapeutic intervention3,5.
Considering that coexistence of CML and PML is a rare disorder, we present a case of a patient with ongoing treatment of CML (BCR-ABL positive) that developed acute promyelocytic leukemia (PML-RARα positive). Cytogenetic findings and a description of the clinical course are explored in the light of recent literature.
No relevant conflicts of interest to declare.
Author notes
Asterisk with author names denotes non-ASH members.

This feature is available to Subscribers Only
Sign In or Create an Account Close Modal